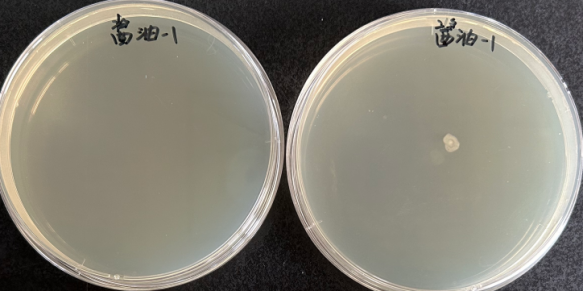
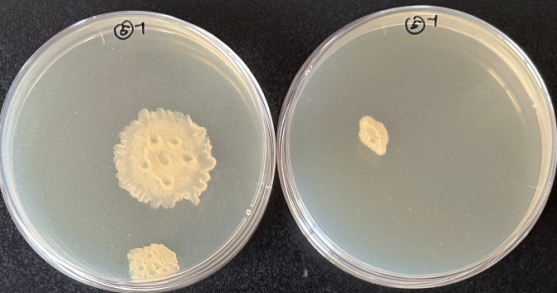

调味品是每一家厨房中的必备品,因为它是菜肴“色香味”俱全的关键。然而,用完后随手放在调料台的蚝油、打开没有盖严的酱油等,这些我们习以为常的使用习惯,可能在悄悄危害家人的身体健康。
你是否在厨房看到过瓶口“披上毛毛”的蚝油、表面星星点点霉斑的黄豆酱、结块的白糖、“哈喇味”的食用油?这些都是调味品不当存放引起的变质。它不仅仅是感官受损,而且潜藏着巨大的安全风险。微生物的滋生会悄悄释放毒素引起食物中毒,吸潮的白糖可能会滋生螨虫,而氧化酸败的油脂更是会有致癌的风险。
很多人会有疑问,明明我的调味品开封没多久,远远没到保质期,为什么会变质?我们首先要了解什么是保质期?保质期指的是预包装食品在标签指明的储存条件下保持品质的期限,并且标签标注的保质期是在未开封的情况下。而当产品开封后,保质期可能会缩短。尤其是在高温、高湿等存放不当的情况下,更是会大打折扣。
那么,我们厨房中的调味品开封后多久会有变质风险?变质的主要风险来源于哪里?如何存放更安全?下面我们来结合科学实验进行一一解答。
一、调味品开封后多久会有变质风险?
从超市购买常用的几种调味品包括酱油、蚝油、黄豆酱、沙拉酱等,我们分别在新开封、高温、高湿环境中存储1周及2周进行了菌落总数、大肠菌群和霉菌酵母菌三个项目的检测。其中大肠菌群和霉菌酵母两个项目在存放过程中都没有生长,但是菌落总数从第1周开始酱油有菌落生长,第2周黄豆酱也开始有菌落生长。
酱油放置一周菌落总数
黄豆酱放置两周菌落总数
二、调味品变质的主要因素是什么?
既然调味品开封后不当存放有风险,是什么原因导致变质呢?调味品变质的主要因素有以下几种:微生物污染、氧化反应、高温高湿、光照、密封不严。很多时候几种因素不是单独存在的,而是共同作用。
微生物污染往往因为产品开封后密封不严,再加上高温高湿的环境造成的。尤其是酱类产品,本身含有丰富的水分、蛋白质、淀粉等,很容易演变成微生物生长的温床。
氧化反应容易在油类调味品密封不严时产生,而高温、光照也会加速氧化反应。
高温高湿环境还会使开封后或散装的盐、糖、味精等吸潮结块,甚至发生微生物和寄生虫污染。
三、调味料如何存放更安全?
我们了解了调味品变质的主要因素,就可以“对症下药”来选择合适的条件进行存放。首先,我们应关注调味品标签内的存储要求,一般来讲:未开封的调味品常温存放,应尽量选择阴凉干燥处,远离灶台、光照、水汽;写有“开封后需冷藏”的调味品,使用后旋紧瓶盖并放进2-8℃冰箱冷藏,低温可让微生物‘冬眠’,也能将香味锁得更久。当然也不是所有的调味品都冷藏最好。下面我们整理了常规调味品的适宜存放条件,让他们对号入座,保持良好风味和安全。
表1 常用调味品的储存条件
|
类别 |
举例 |
存放条件 |
|
酱类 |
蚝油、豆瓣酱、沙拉酱、辣椒酱、番茄酱 |
冷藏、密封 |
|
液体调料 |
酱油、料酒、醋 |
密封、避光、远离灶台。不含添加剂的建议冷藏。 |
|
粉、颗粒状 |
糖、盐、味精、鸡精 |
干燥、密封、防潮 |
|
香辛料 |
花椒、大料、桂皮、香叶 |
干燥、密封、防潮 |
除了关注存放条件,我们还要注意每次取用固体调味料及酱料时,要使用洁净、不含水的勺子,使用后及时擦拭溢洒的瓶口,然后密封保存。而散装和打开后无法密封的调味料要及时转移到密封性好的防潮罐中进行存放。此外,我们每次在使用调味品前都要关注一下他的气味、外观是否正常,一旦出现异常就不要再使用。
让我们记住调味品开盖后保存的三要点:密封防潮防污染、冷藏抑菌锁香、干净免交叉污染,让调味品既安全又耐用!”希望这份详细的指南能帮助您科学管理厨房调味品,守护全家“舌尖上的安全”。一个小小的习惯改变,就能有效避免健康风险。不妨今天就检查一下您家的调味品存放位置是否正确吧!
来源: 中国检验检测学会


 科普中国公众号
科普中国公众号
 科普中国微博
科普中国微博

 帮助
帮助
 中国检验检测学会
中国检验检测学会 
